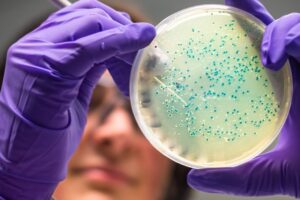
Analiza mikrobiomu jelitowego 1 300x200

Dr n.med. Eryk Matuszkiewicz, lekarz-toksykolog kliniczny Panie Doktorze, czy w gabinecie lekarskim rozmawia się o ziołach jako wsparciu leczenia? Jak to...
ZDROWIE
Zdrowie jelit pod lupąMikrobiom jelitowy – klucz do diagnozowania zmian w jelicie grubymJak mikroflora jelitowa wpływa na zdrowie jelita grubego?Mikrobiom...